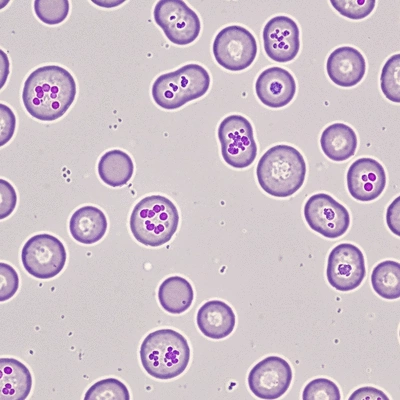
Microscopic view of CMML blood cells

CMMLChronic Myelomonocytic Leukemia
- ✓Chronic onset with more gradual progression.
- ✓Treatment often involves supportive care and targeted therapies.
- ✓Generally has a less favorable outcome compared to AML.
When facing a rare blood disorder like CMML, knowledge can be your greatest ally. Understanding the nuances of this complex condition empowers patients and caregivers to navigate their journey with clarity and confidence. Here's what you'll learn about CMML, a type of leukemia that deserves our attention.
A side-by-side comparison highlighting the key distinctions in onset, treatment, and prognosis between CMML and AML.
Chronic Myelomonocytic Leukemia (CMML) is a rare blood disorder that falls under the umbrella of leukemia. It’s essential to raise awareness about CMML because understanding this specific type of leukemia can empower patients and their families to seek the right information and support. At What Is Leukemia, we aim to provide you with valuable insights into CMML to better navigate this complex condition.
CMML is characterized by a unique blend of features that distinguish it from other forms of leukemia. It exhibits traits of both myelodysplastic syndromes (MDS) and myeloproliferative neoplasms (MPN). This overlap makes CMML particularly challenging to diagnose and treat. Raising awareness about CMML is crucial, not only for patients but also for healthcare professionals who may encounter this rare disorder in their practice.
By understanding CMML and its characteristics, we can work together to demystify this rare leukemia and promote informed discussions about treatment options and patient care.
One of the defining features of CMML is its dual classification. Patients with CMML often show signs of both myelodysplastic and myeloproliferative disorders, which can lead to a range of symptoms. This complexity necessitates a careful evaluation and understanding of how CMML evolves within the body. Patients may experience different degrees of blood cell production abnormalities, which can impact their overall health. For more detailed insights into the nature of CMML as a mixed myelodysplastic/myeloproliferative neoplasm, you can consult resources such as the National Cancer Institute's SEER Program which provides information on hematologic malignancies.
Recognizing these unique features of CMML can greatly assist in the diagnosis and management of this rare disorder, offering hope to those affected.
When comparing CMML to Acute Myeloid Leukemia (AML), there are several important distinctions to note. While both conditions affect blood cell production, they differ significantly in symptoms, treatment approaches, and prognosis. For instance, CMML typically has a more gradual onset compared to the rapid progression seen in AML. The National Cancer Institute provides further details on the treatment of myelodysplastic/myeloproliferative neoplasms, highlighting these differences.
Understanding these differences is crucial for patients and caregivers, as it allows for more informed discussions about treatment options and expected outcomes. As we continue to explore CMML, we aim to equip you with the knowledge needed to navigate your journey.
Did you know? Staying proactive about your health is crucial when dealing with CMML. Regular follow-ups with your healthcare provider, understanding your treatment options, and being aware of any new symptoms can significantly improve your management of this rare leukemia. Don’t hesitate to ask questions and seek clarity on your treatment plan!
As we conclude our exploration of Chronic Myelomonocytic Leukemia (CMML), let’s recap the essential points we've covered. CMML is characterized by its unique overlap with both myelodysplastic and myeloproliferative disorders, making it a challenging diagnosis for many. We’ve discussed its symptoms, such as anemia and infections, as well as the importance of monocytosis in diagnosis.
We've also considered the diagnostic approaches used to identify CMML, including blood tests, bone marrow examinations, and genetic testing. Treatment options range from supportive care to pharmacological treatments like hypomethylating agents and, in some cases, chemotherapy. It's crucial to recognize the importance of risk assessment in determining prognosis and the potential for more personalized treatment plans.
If you or a loved one is navigating a CMML diagnosis, it's vital to connect with healthcare providers who can offer personalized advice tailored to your situation. At What Is Leukemia, we encourage exploring available resources and support networks that can provide both medical and emotional assistance. Engaging with your healthcare team can lead to a deeper understanding of treatment options and help you make informed choices.
Additionally, don't hesitate to reach out to local patient support groups or online communities. Sharing experiences and advice with others who are on a similar journey can be incredibly comforting and empowering. Remember, you are not alone in this process!
Staying updated on the latest advancements in CMML research is crucial for improving patient outcomes. Continuous education and awareness about rare forms of leukemia, like CMML, can lead to better treatment strategies and encourage clinical trials that explore innovative therapies. It's essential to understand that research organizations, such as the National Cancer Institute (NCI) and the American Society of Hematology (ASH), play a pivotal role in advancing our knowledge of this disease.
As a patient or caregiver, consider following these organizations to stay informed about new developments. Engaging in discussions about research findings can empower you to advocate for yourself and your loved ones effectively. At What Is Leukemia, we're committed to providing you with the latest information to demystify CMML and foster hope through education.
Here is a quick recap of the important points discussed in the article:

Understanding leukemia can feel overwhelming, but breaking it down into manageable pieces can make t
Receiving a leukemia diagnosis is often a daunting experience shrouded in uncertainty. The journey c
Being informed about leukemia symptoms can empower you to take proactive steps toward your health. R
As we delve into the complexities of living with leukemia, it's crucial to recognize that this journ